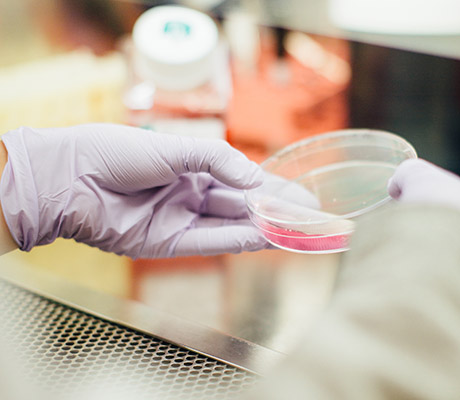

With us, you can keep an eye on the big picture: Whether in industry, as an architectural eye-catcher, in medical technology, in the sports world, or cleverly used in everyday life. With the help of our advice, you will find the perfect solution for your needs!